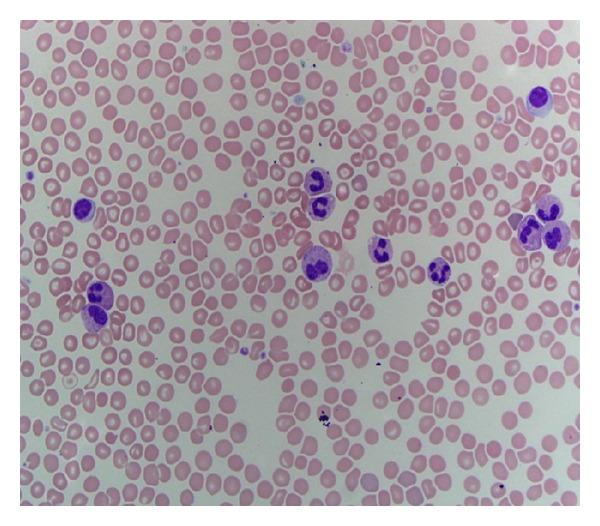
https://cdn.ncbi.nlm.nih.gov/pmc/blobs/e856/4124778/8b4624a8fd92/CRIHEM2014-869395.001.jpg

使用羟基脲、硼替佐米和地塞米松治疗并存的慢性嗜中性粒细胞白血病和轻链多发性骨髓瘤。
Treatment of coexisting chronic neutrophilic leukemia and light chain multiple myeloma with hydroxyurea, bortezomib, and dexamethasone.
作者信息
Taiwo Evelyn, Wang Huiying, Lewis Robert
机构信息
Kings County Hospital Center, 451 Clarkson Avenue, Brooklyn, NY 11203, USA ; State University of New York, Downstate, Brooklyn, NY, USA.
出版信息
Case Rep Hematol. 2014;2014:869395. doi: 10.1155/2014/869395. Epub 2014 Jul 17.
A 63-year-old female was incidentally found to have leukocytosis and referred to the hematology service for evaluation. Complete blood count (CBC) revealed neutrophilia with band predominance and mild thrombocytopenia. Peripheral blood flow cytometry was unremarkable without any evidence of lymphoproliferative disorder or myeloblasts. Bone marrow aspiration and biopsy revealed a markedly hypercellular marrow with myeloid lineage predominance and approximately 10% plasma cells. The monoclonal gammopathy was determined as lambda light chain with a kappa/lambda ratio of 0.06. Cytogenetics revealed normal karyotype, JAK2 kinase was negative, and rearrangement of BCR-ABL1, PDGFRA, PDGFRB, and FGFR1 was negative. The patient was diagnosed with chronic neutrophilic leukemia (CNL) associated with light chain multiple myeloma, complicated by a subdural hemorrhage. She was treated with hydroxyurea and bortezomib/dexamethasone and had complete response with normalization of CBC and kappa/lambda ratio. To the best of our knowledge, we report the first case of chronic neutrophilic leukemia and multiple myeloma treated with bortezomib/dexamethasone.
一名63岁女性偶然发现白细胞增多,遂转诊至血液科进行评估。全血细胞计数(CBC)显示中性粒细胞增多伴杆状核为主,以及轻度血小板减少。外周血流式细胞术未见异常,无任何淋巴细胞增殖性疾病或原始粒细胞的证据。骨髓穿刺和活检显示骨髓明显细胞增多,以髓系为主,约10%浆细胞。单克隆丙种球蛋白病确定为λ轻链,κ/λ比值为0.06。细胞遗传学显示核型正常,JAK2激酶阴性,BCR-ABL1、PDGFRA、PDGFRB和FGFR1重排均为阴性。该患者被诊断为慢性中性粒细胞白血病(CNL)合并轻链多发性骨髓瘤,并发硬膜下出血。她接受了羟基脲和硼替佐米/地塞米松治疗,CBC和κ/λ比值恢复正常,达到完全缓解。据我们所知,我们报告了首例用硼替佐米/地塞米松治疗的慢性中性粒细胞白血病和多发性骨髓瘤病例。